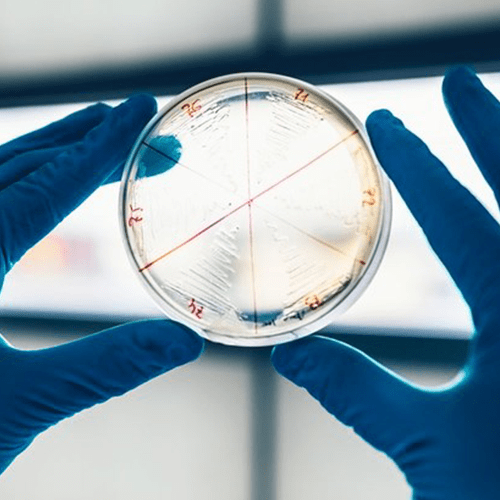

Avisos & Informações

Título 1
In our work we try to use only the most modern, convenient and interesting solutions 1

Título 2
In our work we try to use only the most modern, convenient and interesting solutions 2

Título 3
In our work we try to use only the most modern, convenient and interesting solutions 3
Missão
O Centro Qualifica do Agrupamento de Escolas de Alcanena tem como missão contribuir, na sua área geográfica de intervenção, para o elevar das qualificações da população, através não só da conclusão da escolaridade, mas também de vários tipos de formação, incluindo certificações profissionais.
À chegada ao Centro é feito um diagnóstico do perfil de cada interessado e a partir daí procede-se ao encaminhamento para a modalidade formativa mais adequada ou para um Processo de Reconhecimento, Validação e Certificação de Competências (RVCC), no caso de o candidato à certificação ter uma experiência de vida que lhe permitiu adquirir as competências exigidas pelo referencial de RVCC.